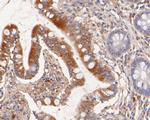
Nhe-1 Antibody in Immunohistochemistry (Paraffin) (IHC (P))
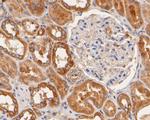
Nhe-1 Antibody in Immunohistochemistry (Paraffin) (IHC (P))

Search
Invitrogen
Nhe-1 Polyclonal Antibody
{{$productOrderCtrl.translations['antibody.pdp.commerceCard.promotion.promotions']}}
{{$productOrderCtrl.translations['antibody.pdp.commerceCard.promotion.viewpromo']}}
{{$productOrderCtrl.translations['antibody.pdp.commerceCard.promotion.promocode']}}: {{promo.promoCode}} {{promo.promoTitle}} {{promo.promoDescription}}. {{$productOrderCtrl.translations['antibody.pdp.commerceCard.promotion.learnmore']}}
图: 1 / 8
Nhe-1 Antibody (PA5-116471) in ICC/IF

Please note: We are reviewing Western blot images included in the antibody testing data in our catalog, including those provided by third parties. Unless expressly labeled or annotated as “raw-unedited”, Western blot images included in the antibody testing data in our catalog may have been edited, optimized or otherwise adjusted for presentation.
产品信息
PA5-116471
种属反应
宿主/亚型
分类
类型
抗原
偶联物
形式
浓度
规格
纯化类型
保存液
内含物
保存条件
运输条件
RRID
产品详细信息
Positive controls: Rat skin lysates, A431, 293T, LOVO, human kidney tissue, mouse colon tissue, human small intestine tissue.
靶标信息
The Na+/H+ antiporter (Nhe-1) is a ubiquitous membrane-bound enzyme involved in pH regulation of vertebrate cells and is specifically inhibited by the diuretic drug amiloride and activated by a variety of signals including growth factors, mitogens, neurotransmitters, and tumor promoters. Nhe-1 acts as an anchor for actin filaments to control the integrity of the cortical cytoskeleton. This occurs through a previously unrecognized structural link between Nhe-1 and the actin-binding proteins ezrin, radixin, and moesin, collectively referred to as ERM proteins. A structural role for Nhe-1 has been proposed in regulating the cortical cytoskeleton that is independent of its function as an ion exchanger. It is also thought that Nhe-1 play a role in hypertension. At least two isoforms of Nhe-1 are known to exist.
仅用于科研。不用于诊断过程。未经明确授权不得转售。
篇参考文献 (0)
生物信息学
蛋白别名: APNH; Na(+)/H(+) antiporter, amiloride-sensitive; Na(+)/H(+) exchanger 1; Na+/H+ antiporter; Na+/H+, amiloride sensitive; NHE-1; slow-wave epilepsy; Sodium/hydrogen exchanger 1; Solute carrier family 9 (sodium/hydrogen exchanger 1), antiporter, Na+/H+, (amiloride sensitive); solute carrier family 9 (sodium/hydrogen exchanger), member 1; Solute carrier family 9 member 1; solute carrier family 9, member 1
基因别名: Apnh; APNH1; AW554487; mir-5122; Mir5122; NHE1; SLC9A1; swe
UniProt ID: (Rat) P26431, (Mouse) Q61165
Entrez Gene ID: (Rat) 24782, (Mouse) 20544




